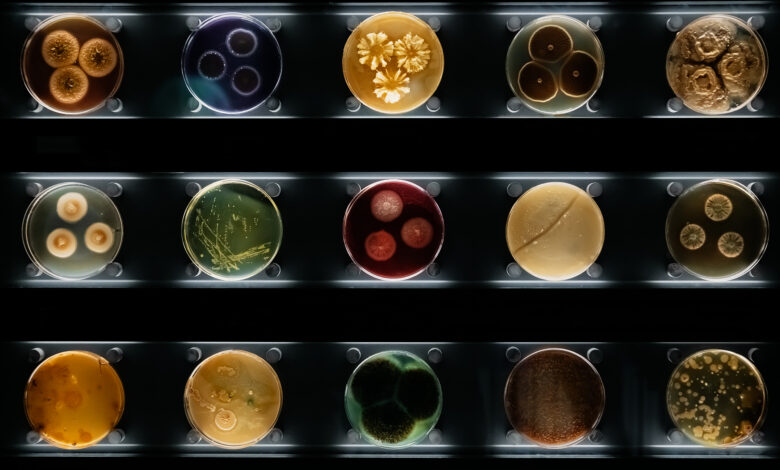
Antibiyotik direnci

Antibiyotik Direnci
Bakteriler, belli bir antibiyotiğe sürekli maruz kaldıklarında, o antibiyotiğe karşı direnç göstermeye başlarlar ve bir süre sonra antibiyotiğin o bakteri türü üzerindeki etkisi yok olur. Evrimciler, bazı bakterilerin antibiyotiklere karşı direnç göstermelerini evrime delil olarak gösterirler. Bu direncin bakterilerde meydana gelen mutasyonlar sonucunda geliştiğini iddia ederler. Oysa bakterilerde meydana gelen direnç, onların mutasyon sonucunda sonradan geliştirdikleri bir özellik değildir. Çünkü bakteriler bu özelliğe antibiyotiğe maruz kalmadan önce de sahiptirler. Scientific American dergisi, evrimci bir yayın olmasına karşın, Mart 1998 sayısında bu konuda şöyle bir açıklamaya yer vermiştir:
Çok sayıda bakteri, daha ticari antibiyotikler kullanılmaya başlamadan önce de direnç genlerine sahipti. Bilim adamları bu genlerin neden evrimleştiklerini ve varlıklarını sürdürdüklerini kesinlikle bilmiyorlar.21
Görüldüğü gibi, direnç sağlayan genetik bilginin, antibiyotiklerden önce var olması, evrimciler tarafından açıklanamayan ve teorinin iddiasını geçersiz kılan bir gerçektir.

Dirençli bakterilerin, antibiyotiklerin keşfinden yıllarca önce mevcut olduğu, ciddi bir bilimsel yayın olan Medical Tribune dergisinin 29 Aralık 1988 tarihli sayısında da, ilginç bir olay aktarılarak şöyle belirtilmektedir:
1986’da yapılan bir araştırmada, 1845 yılında bir kutup keşfi sırasında hastalanarak hayatını kaybeden denizcilerin buzda korunmuş cesetleri bulunmuştur. Bu cesetlerin üzerinde 19. yüzyılda yaygın olan bazı bakteri çeşitleri tespit edilmiş ve bunlar test edildiğinde, 20. yüzyılda üretilmiş pek çok modern antibiyotiğe karşı direnç özellikleri taşıdıkları hayretle saptanmıştır.22

Bu tür direnç özelliklerinin penisilinin icadından önce de birçok bakteri türünde mevcut olduğu, tıp dünyasında bilinen bir gerçektir. Dolayısıyla bakterilerdeki direnç özelliğinin evrimsel bir gelişme gibi öne sürülmesi kesinlikle yanlış bir iddiadır.
Günlük dilde “bakterilerin bağışıklık kazanması” denen süreç gerçekte şöyle oluşur:
Bakterilerin kendi türleri içinde sayısız varyasyonları (çeşitleri) vardır. Bu varyasyonların bir kısmı, yukarıda belirtildiği gibi, bazı ilaçlara karşı direnç sağlayacak genetik bilgiye sahiptir. Bakteriler belli bir ilacın etkisine maruz kaldıklarında, ilaca dayanıksız varyasyonlar yok olur; dirençliler ise hayatta kalır ve daha fazla çoğalma imkanına kavuşurlar. Belli bir zaman sonra tamamen yok olan dirençsiz bakterilerin yerini, hızla çoğalan bu dirençli bakteriler doldurur. Bir süre sonra, aynı bakteri türü yalnızca söz konusu antibiyotiğe dirençli olan bireylerden oluşmuş bir koloni haline gelir ve artık aynı antibiyotik o bakteri türüne karşı etkisiz olur. Ancak bakteri yine aynı bakteri, tür yine aynı türdür. Herhangi bir evrim yaşanmamıştır.
KAYNAKÇA
21 Stuart B. Levy, “The Challange of Antibiotic Resistance”, Scientific American, March 1998, s.35
22 Medical Tribune, 29 December 1988, s.1, 2





